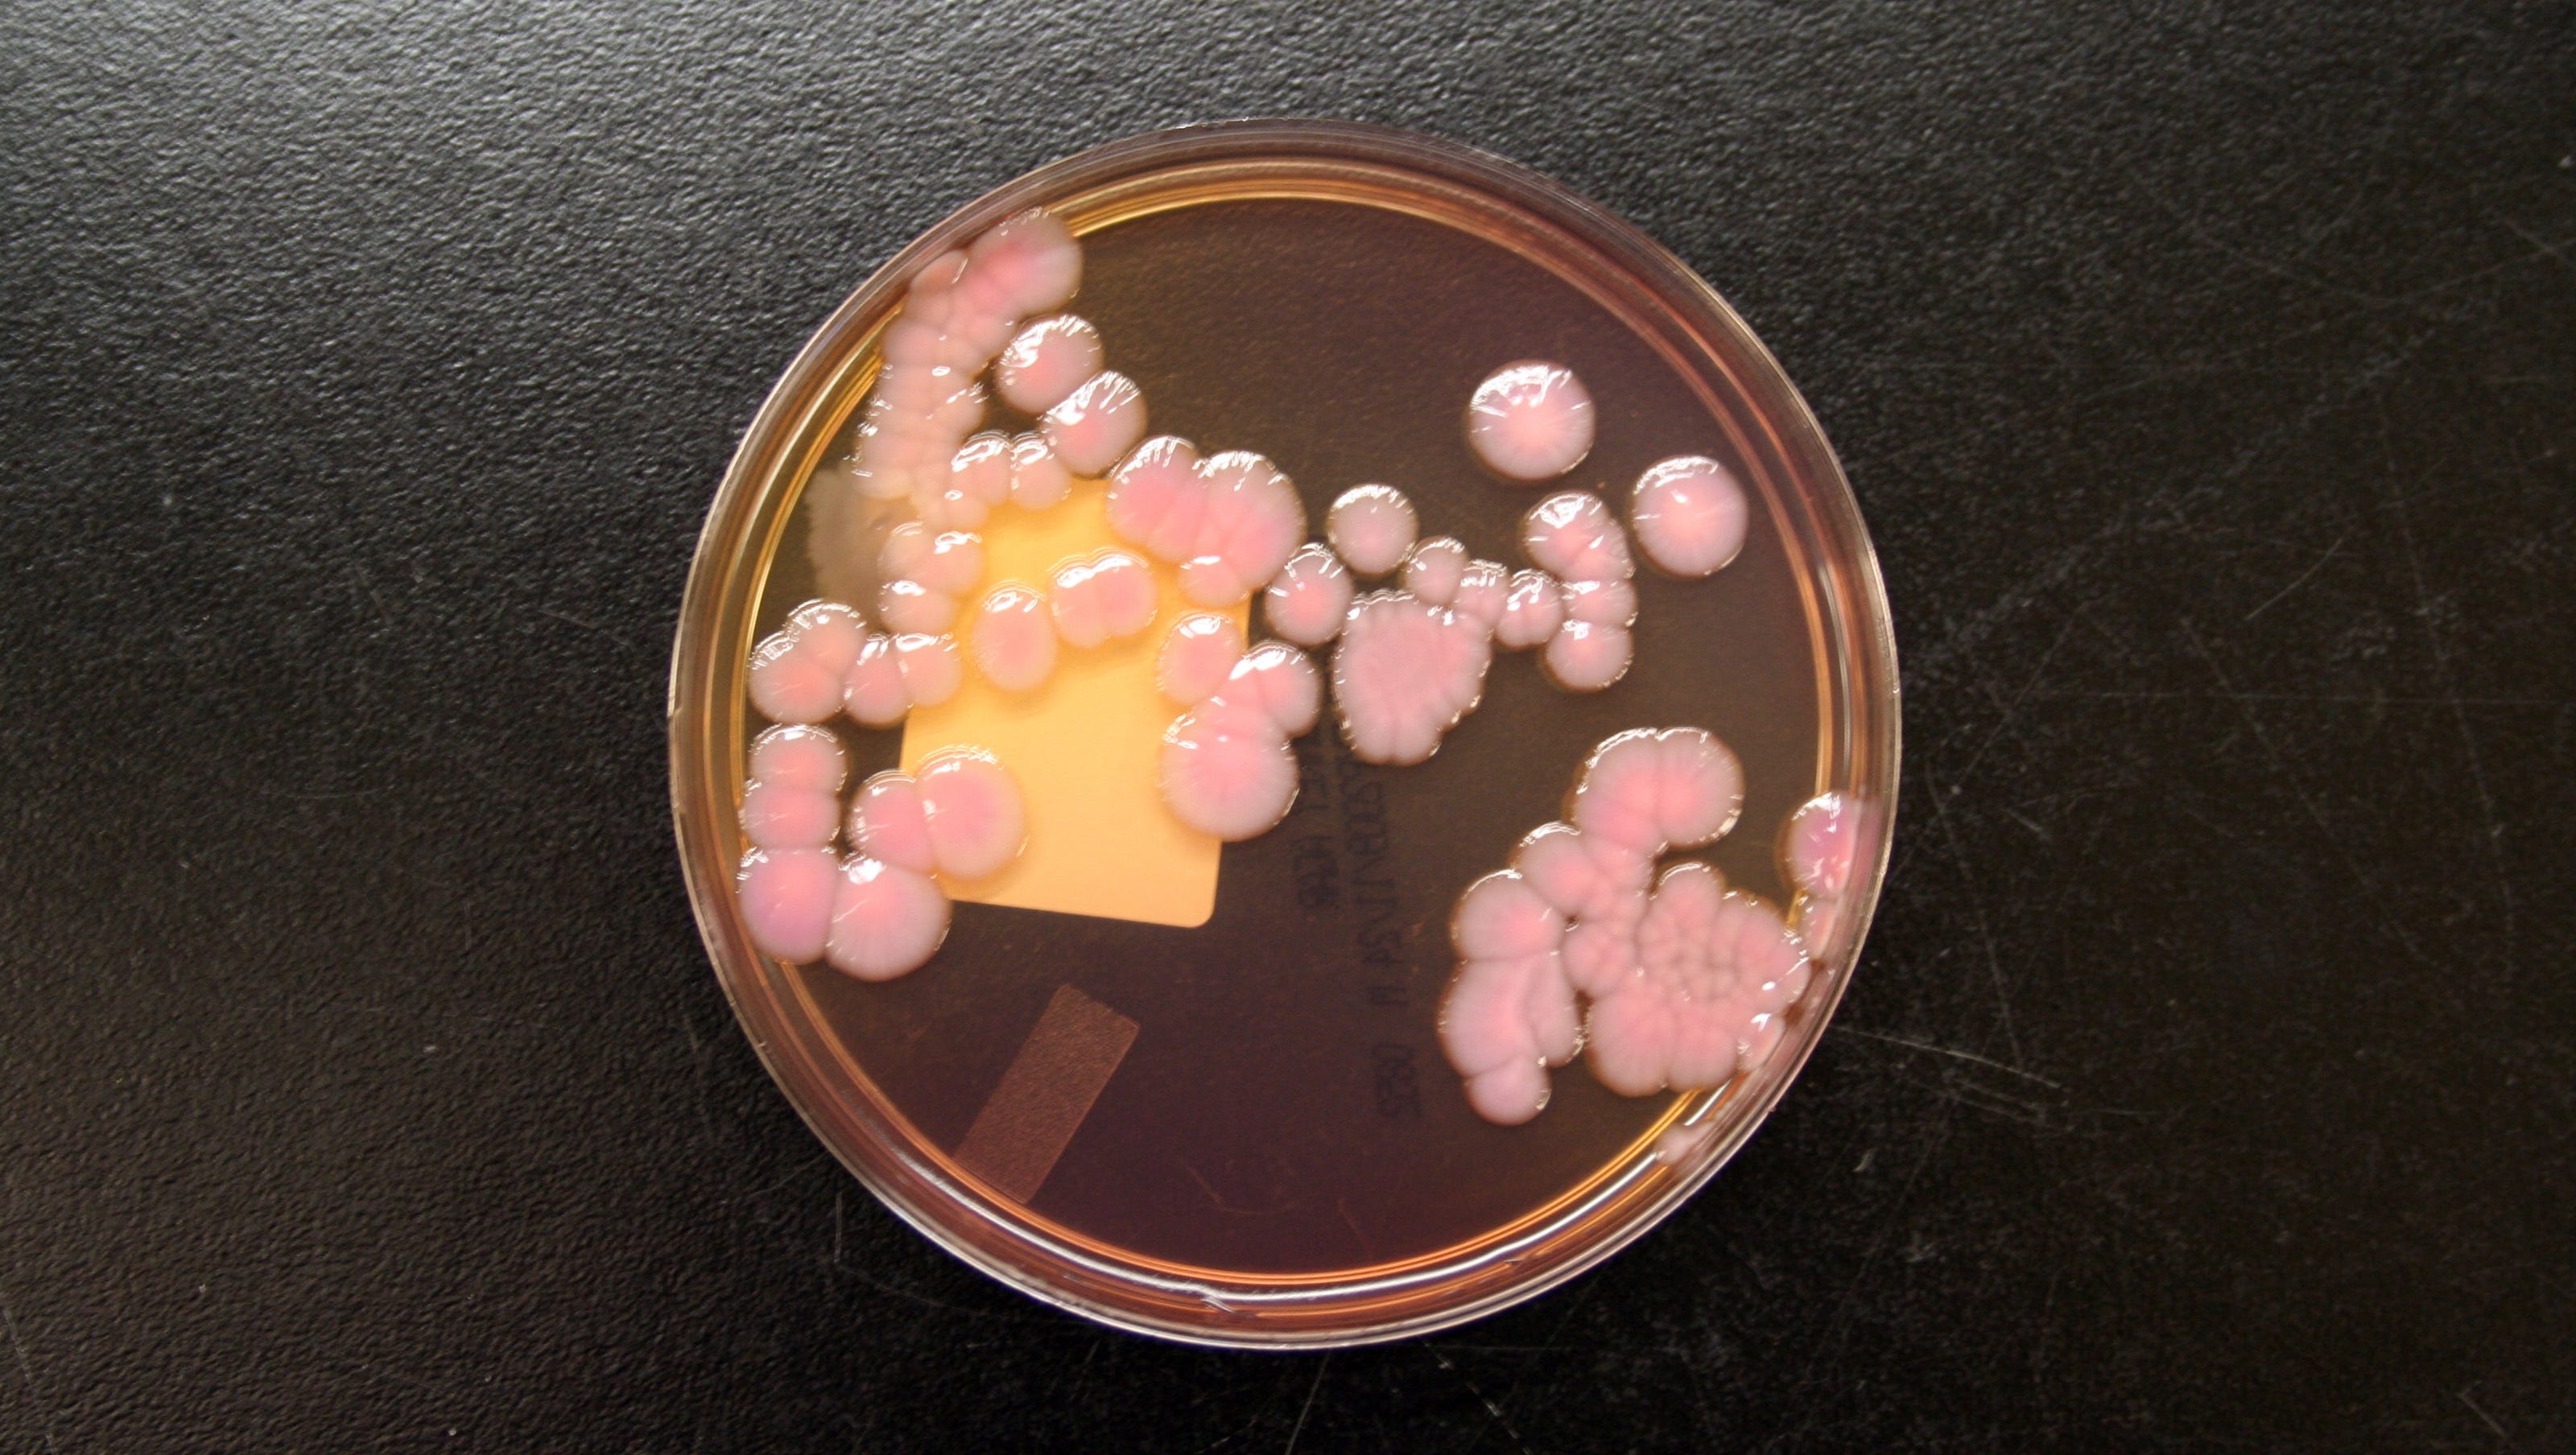

Important! What Are Superbugs Why Are They So Dangerous
These drug resistant bacteria and fungi are difficult to control and. Almost 30 thousand people in the US die of C.

The Arms Race Between Germs And Medicine How Superbugs Have Taken The Lead And How Humans Can Take It Back Science In The News
Diff every year and this statistic is even more concerning when you consider that many C.

What are superbugs why are they so dangerous. Superbugs are strains of bacteria viruses parasites and fungi that are resistant to most of the antibiotics and other medications commonly used to treat the infections that they causeSince the inception of antibiotics the bacteria they treat have been adapting and changing in order to build up resistance. They are also extra dangerous to those who have compromised immune systems. 52 years ago Science Jobs in Space.
There are no effective treatments Coombes says. There are still relatively few cases of CRE in Canada compared to other so. Superbugs arent really as much super as they are more resistant.
Learn vocabulary terms and more with flashcards games and other study tools. This has led to the rise of multi-drug resistant superbugs. They can cause life-threatening blood infections.
A superbug is a form of bacteria that is resistant to antibiotics which is a form of medicine that we normally use to treat these things. Why theyre dangerous where they are and how they spread. Superbugs evolve when the germs including bacteria and fungi become resistant to nearly all of.
In this podcast Dr. Here are four of the most dangerous superbugs out there. Diff is a dangerous infection that causes severe inflammation cramping and diarrhea.
Superbugs pose the most risk to healthcare facilities like hospitals. Out of those 2 million Americans infected each year from antibiotic-resistant bacteria 23000 dies. Dan discovers more about what superbugs are and why theyre so dangerous.
Dan discovers more about what superbugs are and why theyre so dangerous Jobs Job Description. What are superbugs and why are they so dangerous. Superbugs are germs that have become resistant to the drugs that should destroy them.
They can cause infections that are difficult -- or sometimes impossible -- to treat. 5 Common Superbug Infections Caused by Bacteria. Answer From Pritish K.
For more information on taking antibiotics responsibly and bacterial infections visit the Get Healthy Stay. A few examples of superbugs include resistant bacteria that can cause pneumonia urinary tract infections and skin infections. Start studying science study guide.
Some are resistant to one or two but others can be resistant to multiple drugs. Superbugs are strains of bacteria viruses parasites and fungi that are resistant to most of the antibiotics and other medications commonly used to treat the infections they cause. Diff if youve taken antibiotics recently.
1 Methicillin-resistant Staphylococcus aureus MRSA MRSA is a type of antibiotic-resistant bacteria that usually causes skin infections but can also cause fatal lung infections pneumonia and bloodstream infections sepsis without treatment. Diff infections are resistant to common antibiotics. This week Dans chatting to Sheldon Paquin who curated the Superbugs exhibition thats going on at the Science Museum in London at the moment.
John Ross assistant. The number of different antibiotics to which it can be resistant determines the degree of the superbug. Heres why the rise of superbugs is so dangerous.
Superbugs are strains of bacteria that are resistant to several types of antibiotics. The Doctors are joined by Pfizers Chief Medical Officer Dr. Ironically you have a higher risk of developing C.
Why are they so dangerous. Superbugs are resistant to all or most tested antibiotics and are uncommon or carry special resistance genes that are constantly developing and spreading. Each year these drug-resistant bacteria infect more than 2 million people nationwide and kill at least 23000 according to the US.
Scientists have difficulty designing more potent antibiotics because all drugs have. While antibiotic resistance can have a variety of causes the end result is that weak bacteria are killed leaving behind resilient strains capable of producing untreatable infections. Centers for Disease Control and Prevention CDC.
Antibiotic resistance has been called one of the worlds most pressing public health problems. A superbug is a form of bacteria that is resistant to antibiotics which is a form of medicine that we normally use to treat these things. Dangerous superbugs kill more people than previously thought.
CRE superbugs are becoming more widespread in hospitals and other healthcare facilities. Superbugs are particularly threatening because they are so difficult to treat but theyre also extremely contagious in many cases. What is a superbug.
A superbug is usually defined as a microorganism thats resistant to commonly used antibiotics - but not all superbugs are created equal. The smart use of antibiotics is the key to controlling the spread of antibiotic resistant bacteria and the rise of superbugsbacteria that cause infections that are difficult if not impossible to treat. The more antibiotics are used the less effective they become.
Most commonly superbugs are bacteria that survive antibiotics. Some research says that up to 50 of patients who are sick from CRE die. Freda Lewis-Hall to explain what superbugs are and why they are so dangerous.

The Energy Boosting Hormone Balancing Enzyme You Need To Know About Holistic Health Remedies Holistic Health Holistic Remedies

The War Against Superbugs Hospital News

What Is A Superbug Live Science

Earliest Known Case Of Antibiotic Resistant Superbug Found In Ny
![]()
There S A Superbug Outbreak In California But It S Really A Global Problem Vox

Superbugs 7 Things To Know About Your Risk

World Economic Forum On Twitter Antimicrobial Resistance Antibiotic Bacterial Infection

Scary New Superbug Is Popping Up In More Places Essential Oils For Diarrhea Yeast Infection Small Intestine Bacterial Overgrowth

Nightmare Bacteria Are Trying To Spread In The U S Cdc Says

Superbug Known As Phantom Menace On The Rise In U S Antibiotic Sociopathic Behavior Bacteria

Superbugs Types Symptoms Treatment Prevention
Cdc Sounds Alarm On Deadly Untreatable Superbugs

Drug Resistant Superbugs Kill Someone Every 15 Minutes In The Us New Cdc Report Reveals Cnn

Is Coronavirus The Long Feared Superbug Safespace

Antibiotic Resistance Arises When Bacteria Change To Protect Themselves Against An Antibiotic What Does Infographic Health Antimicrobial Resistance Antibiotic

7 Of The Deadliest Superbugs All Media Content Dw 31 07 2019

Fatal Superbugs Antibiotics Losing Effectiveness Who Says

Scientists Find A Weak Spot In Some Superbugs Defenses Wired

Infographic Antibiotic Resistance Antibiotic Infographic Super Mom